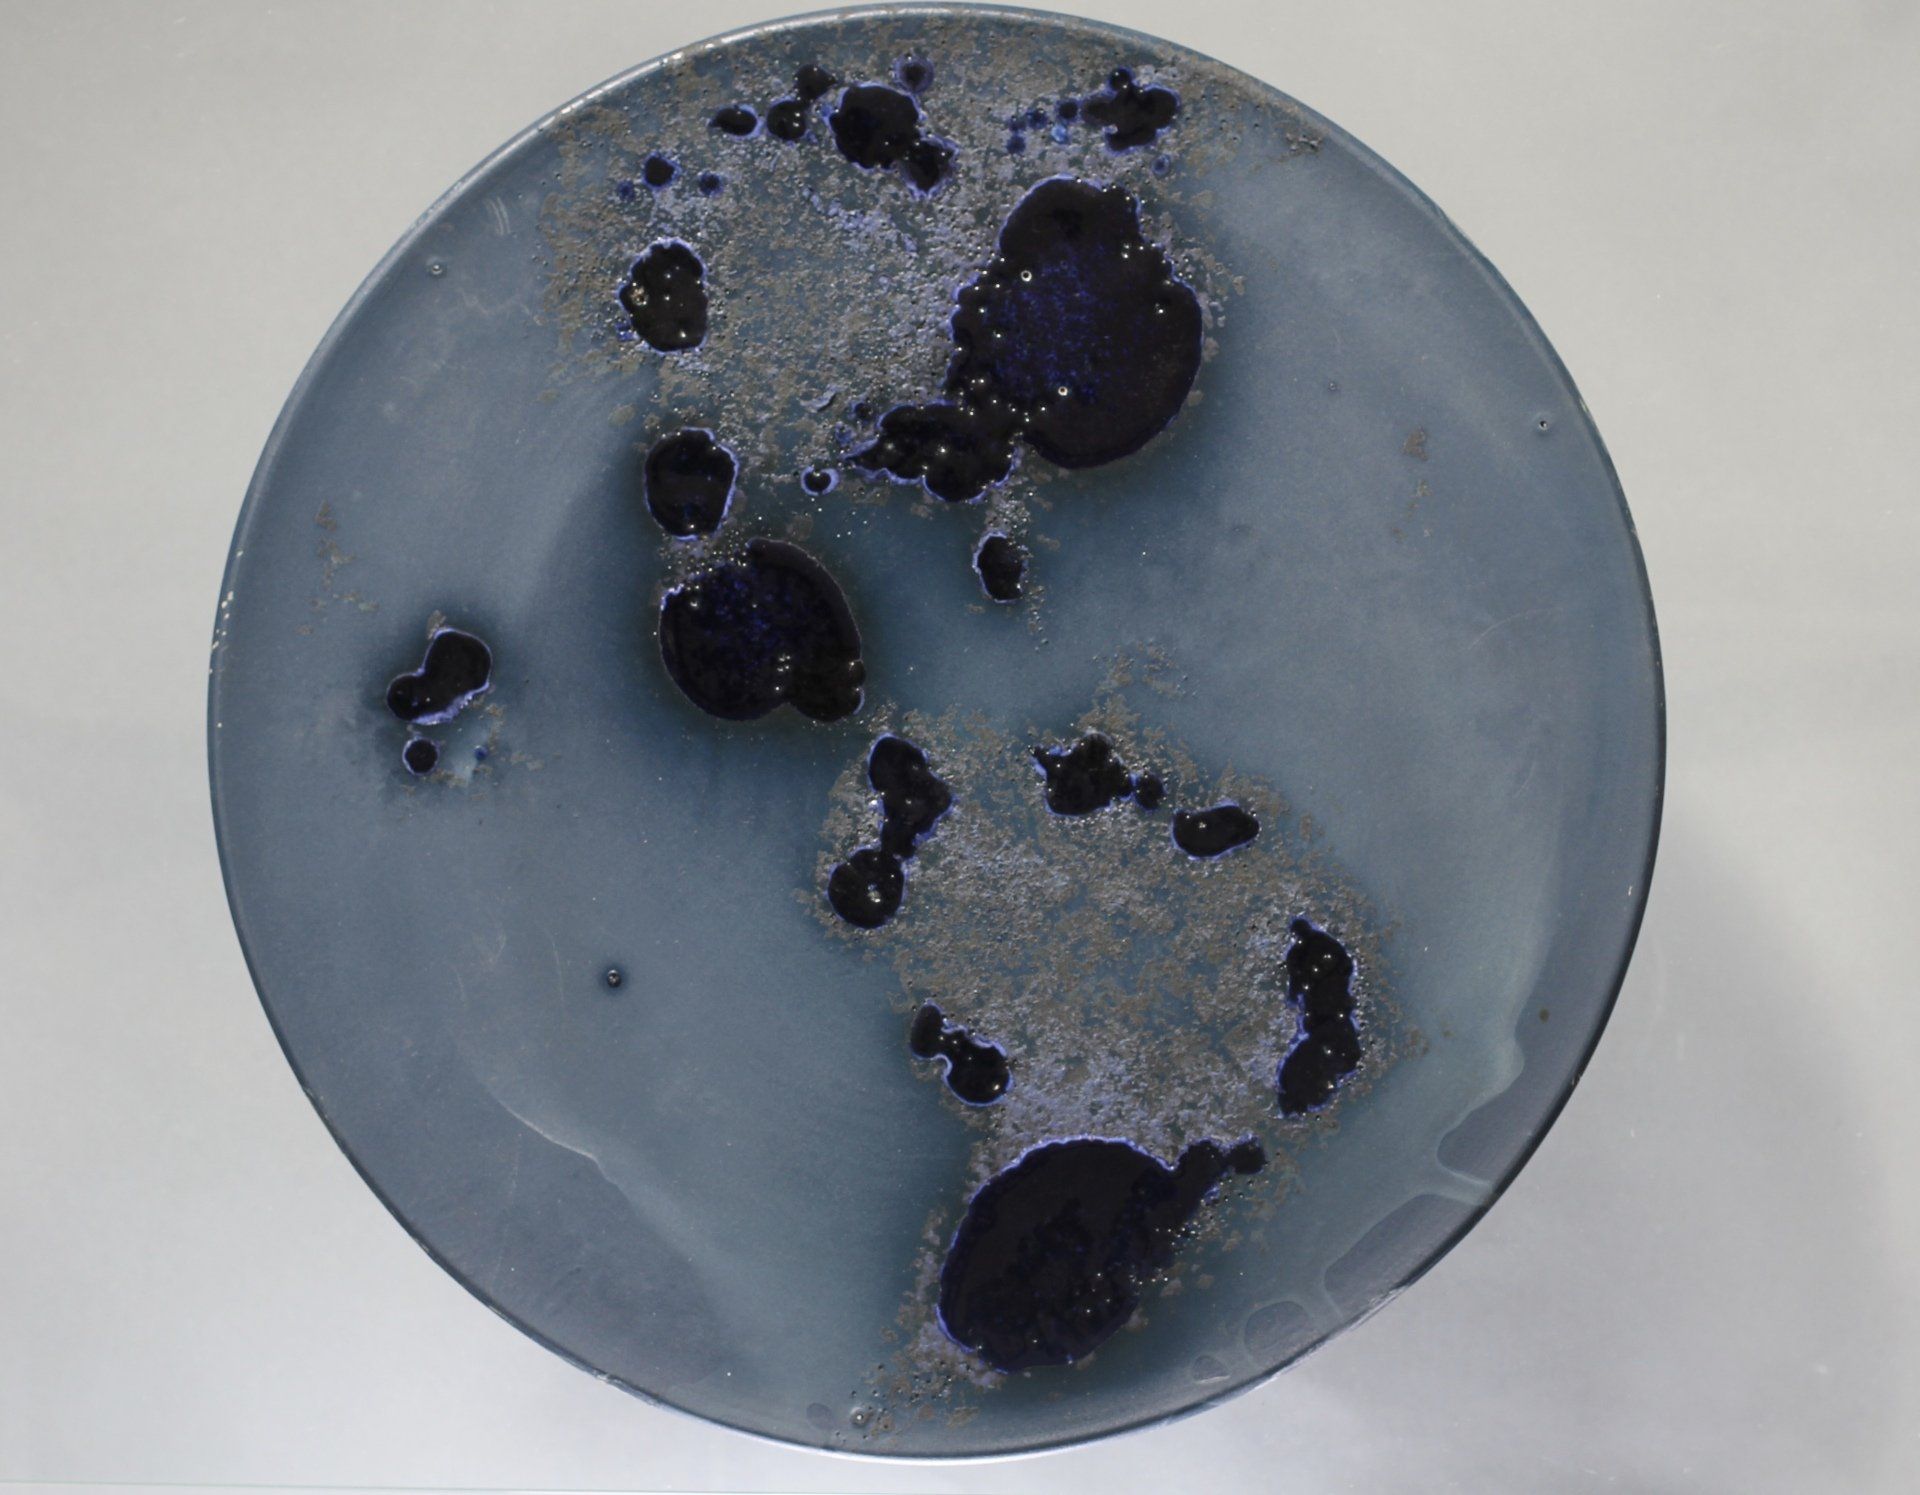
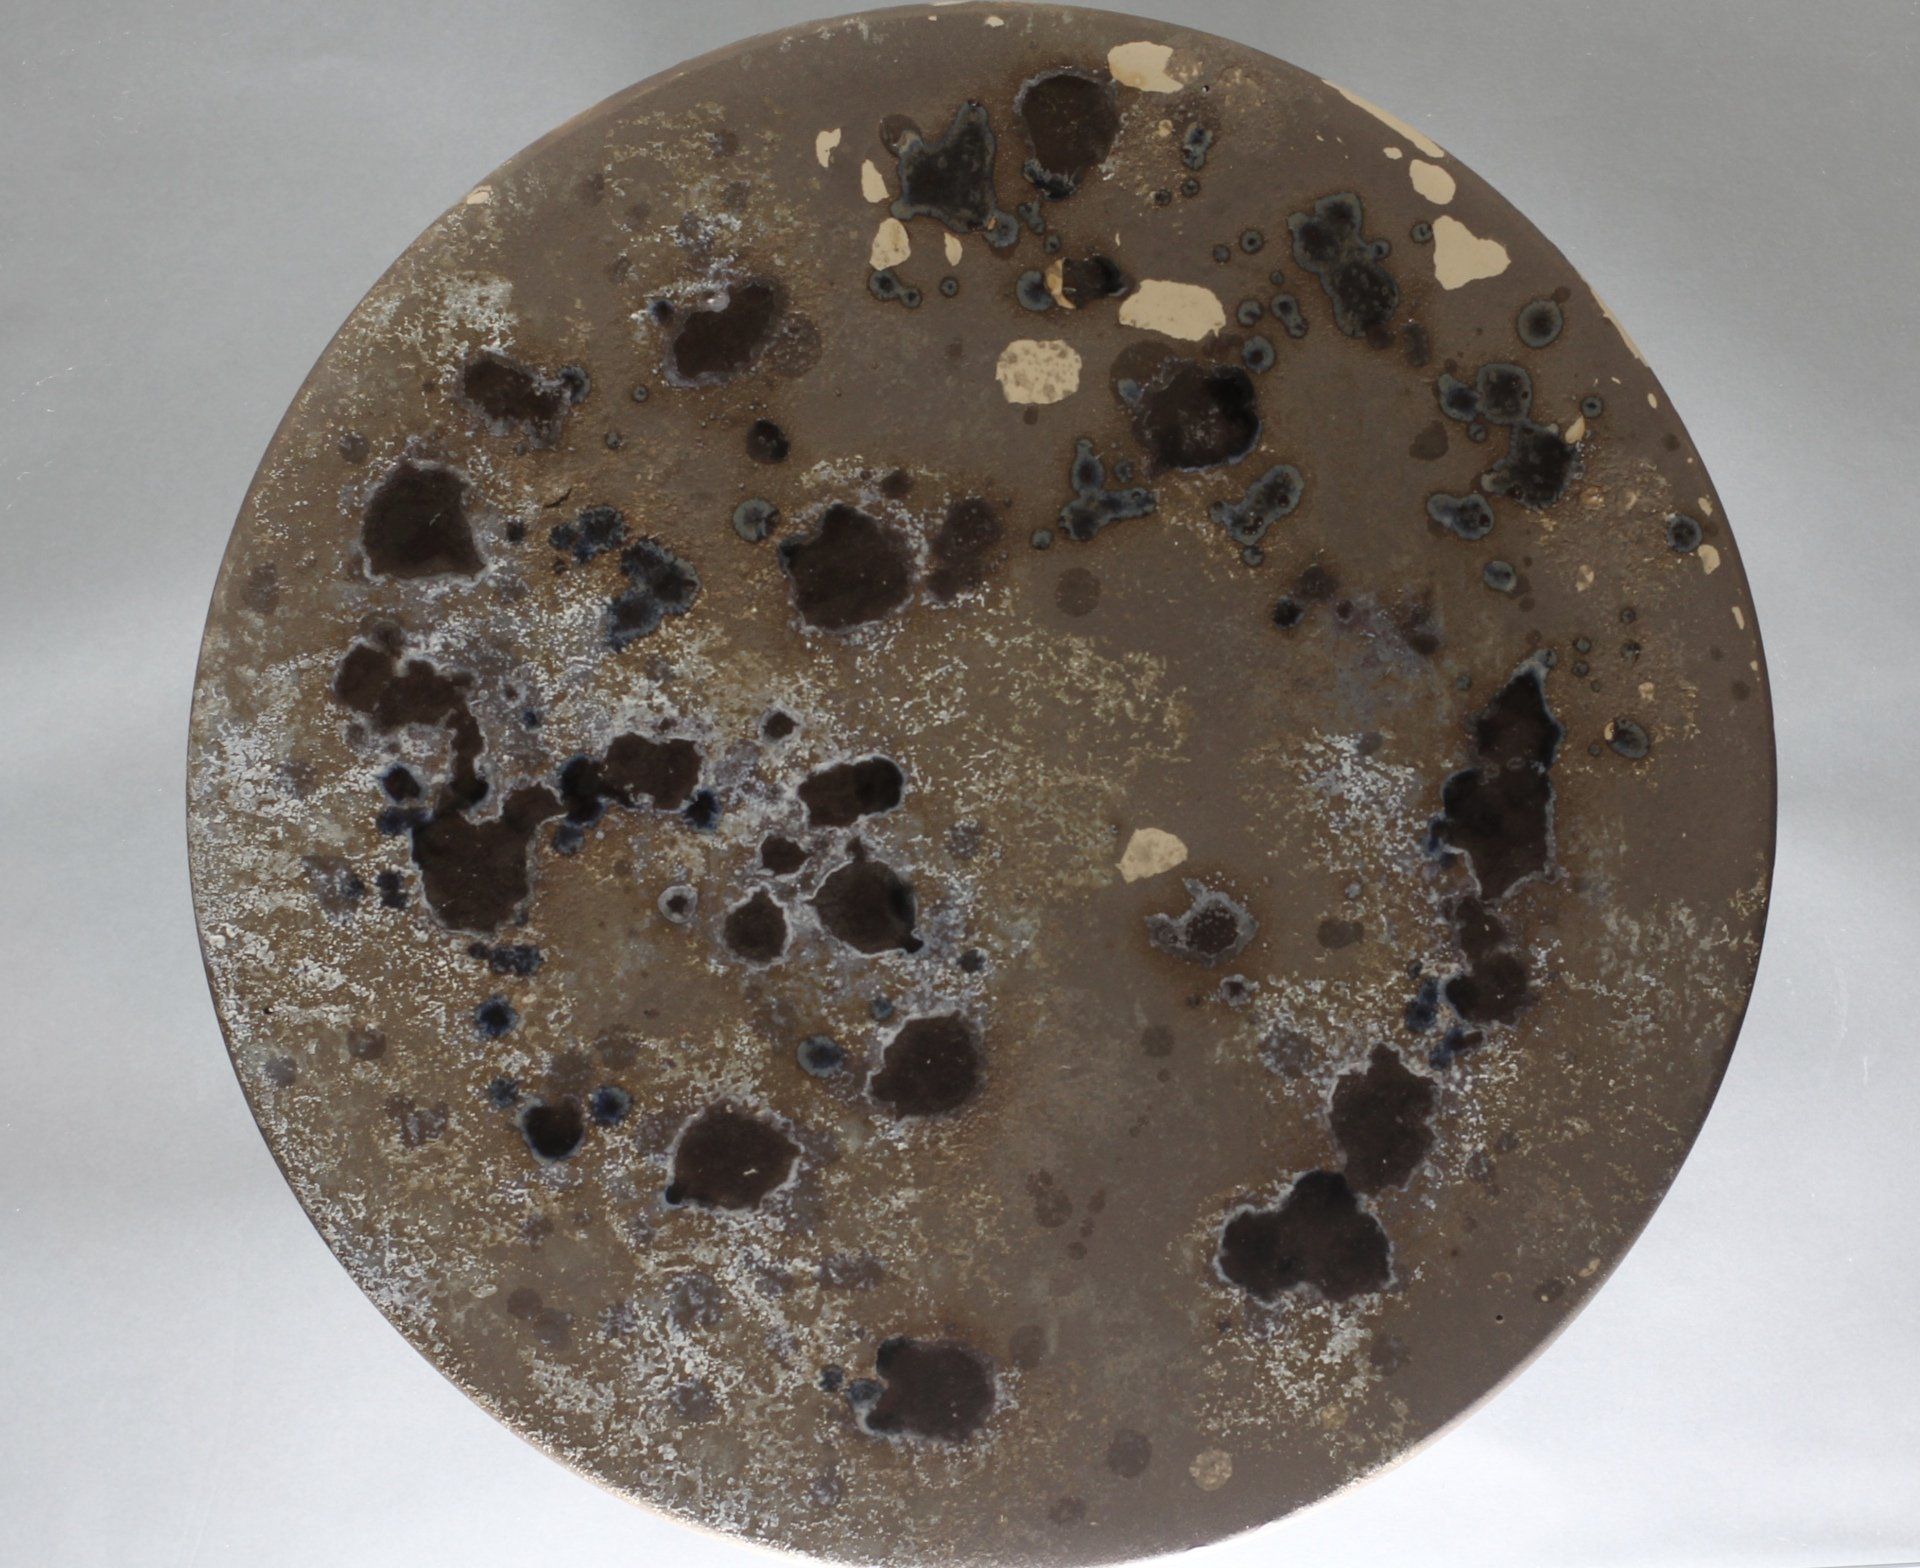

Bildplatten
Die Formlosigkeit der Kreisscheibe bietet eine reine Fläche. Auf der Drehscheibe ziehe ich mit meinem Material Kreise, breite es wie Wasserwellen aus, bis zur jeweiligen Maximalgrenze ( diese liegt zwischen 20 und 50 cm ).
Unabhängig von ihrer Funktionalität, setze ich mich mit den dünn gedrehten Steinzeugscheiben bildhaft in meiner Engobetechnik auseinander. Mit einer besonderen Ritztechnik fließen zeichnerische Elemente und Aktdarstellungen ein.
Es gehen zum Teil Skizzen voraus, viele Zeichnungen entstehen aber auch direkt bei den Performances und hinterlassen so dynamische Spuren der Bewegung im Material.